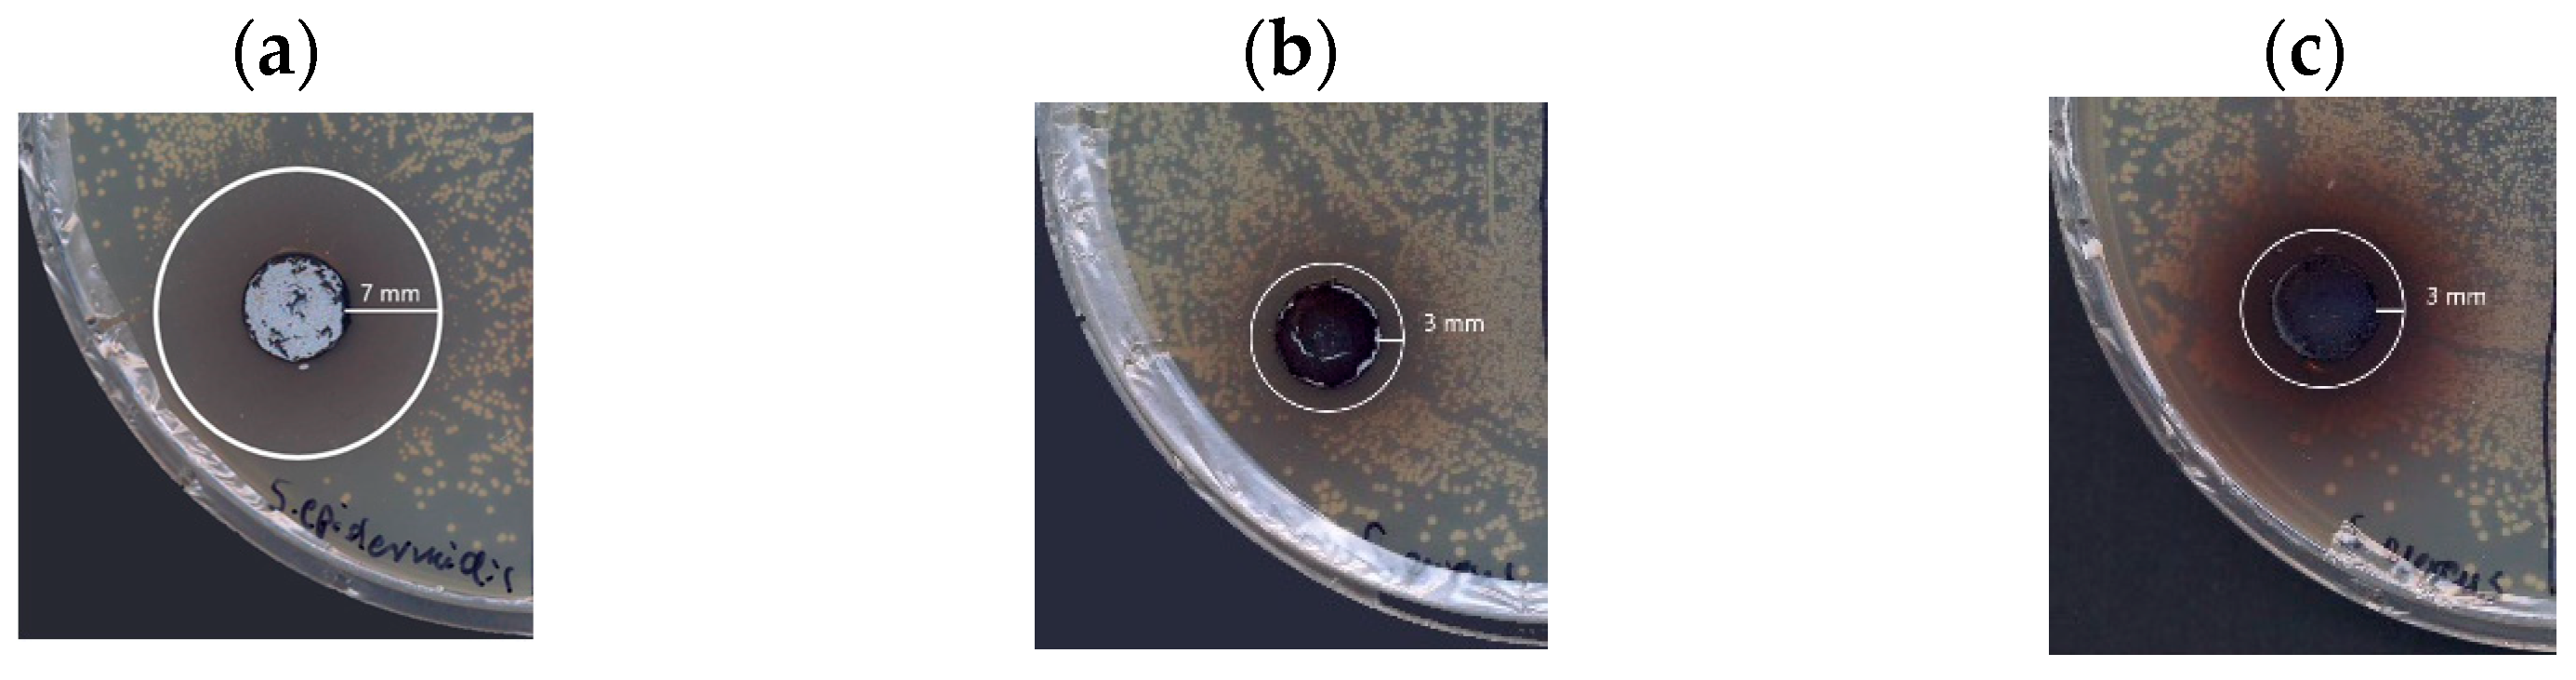
Molecules 29 01310 g008

Synthesis and Bioactive Properties of the Novel Coloured Compound Obtained via the Laccase-Mediated Transformation of 5-Aminosalicylic Acid
Abstract
1. Introduction
2. Results and Discussion
2.1. Optimisation of 5-Aminosalicylic Acid Oxidation
2.1.1. Influence of pH and Co-Solvent Addition on the Oxidation of 5-ASA
2.1.2. Influence of Acetonitrile and Buffer Concentrations on the Oxidation of 5-ASA
2.1.3. Influence of Laccase Activity on the Oxidation of 5-ASA
2.2. Bioactive Properties of 5-ASA Oxidation Products
2.2.1. Antimicrobial Properties
2.2.2. Antioxidative Properties
2.3. Toxicity of Substrate and Oxidation Products
2.4. Dyeing and Irritating Properties of the 5-ASA Oxidation Product
3. Materials and Methods
3.1. Chemicals and Co-Solvents
3.2. Laccase Assay
3.3. Substrate Characterisation
3.4. Biotransformation of Substrate 5-ASA by Fungal Laccase—Optimisation Process
3.5. HPLC Analysis of the Transformation Mixture
3.6. Properties of Dye
3.6.1. Antimicrobial Properties
3.6.2. Antioxidant Properties
3.6.3. Toxicity
Cytotoxicity
Environmental Toxicity
3.6.4. Dyeing Properties
3.6.5. Allergenicity Patch Test
3.6.6. Statistical Analysis
4. Conclusions
Author Contributions
Funding
Institutional Review Board Statement
Informed Consent Statement
Data Availability Statement
Acknowledgments
Conflicts of Interest
References
- Christaki, E.; Bonos, E.; Giannenas, I.; Florou-Paneri, P. Aromatic plants as a source of bioactive compounds. Agriculture 2012, 2, 228–243. [Google Scholar] [CrossRef]
- Newman, D.J.; Cragg, G.M. Natural products as sources of new drugs from 1981 to 2014. J. Nat. Prod. 2016, 79, 629–661. [Google Scholar] [CrossRef] [PubMed]
- Bassanini, I.; Ferrandi, E.E.; Riva, S.; Monti, D. Biocatalysis with laccases: An updated overview. Catalysts 2021, 11, 26. [Google Scholar] [CrossRef]
- Sousa, A.C.; Martins, L.O.; Robalo, M.P. Laccases: Versatile biocatalysts for the synthesis of heterocyclic cores. Molecules 2021, 26, 3719. [Google Scholar] [CrossRef]
- Hahn, V. Potential of the enzyme laccase for the synthesis and derivatization of antimicrobial compounds. Word J. Microbiol. Biotechnol. 2023, 39, 107. [Google Scholar] [CrossRef] [PubMed]
- Kudanga, T.; Nemadziva, B.; Le Roes-Hill, M. Laccase catalysis for the synthesis of bioactive compounds. Appl. Microbiol. Biotechnol. 2017, 101, 13–33. [Google Scholar] [CrossRef]
- Polak, J.; Wlizło, K.; Pogni, R.; Petricci, E.; Graz, M.; Szałapata, K. Structure and bioactive properties of novel textile dyes synthesised by fungal laccase. Int. J. Mol. Sci. 2020, 21, 2052. [Google Scholar] [CrossRef]
- Pezzela, C.; Giacobbe, S.; Giacobelli, V.G.; Guarino, L.; Kylic, S.; Sener, M.; Sannia, G.; Piscitelli, A. Green routes towards industrial textile dyeing: A laccase based approach. J. Mol. Catal. B Enzym. 2016, 134, 274–279. [Google Scholar] [CrossRef]
- Polak, J.; Jarosz-Wilkołazka, A. Structure/redox potential relationship of simple organic compounds as potential precursors of dyes for laccase-mediated transformation. Biotechnol. Prog. 2012, 23, 93–102. [Google Scholar] [CrossRef]
- Kaufman, J.; Griffiths, T.A.; Surette, M.G.; Ness, S.; Rioux, K.P. Effects of mesalamine (5-aminosalicylic acid) on bacterial gene expression. Inflamm. Bowel Dis. 2009, 15, 985–996. [Google Scholar] [CrossRef]
- Olaisen, M.; Spigset, O.; Flatberg, A.; Granlund, A.V.B.; Brede, W.R.; Albrektsen, G.; Royset, E.S.; Gilde, B.; Sandvik, A.K.; Martinsen, T.C.; et al. Mucosal 5-aminosalicylic acid concentration, drug formulation and mucosal microbiome in patients with quiescent ulcerative colitis. Aliment. Pharmacol. Ther. 2019, 49, 1301–1313. [Google Scholar] [CrossRef] [PubMed]
- Xu, F. Effects of redox potential and hydroxide inhibition on the pH activity profile of fungal laccases. J. Biol. Chem. 1997, 272, 924–928. [Google Scholar] [CrossRef] [PubMed]
- Rodakiewicz-Nowak, J.; Kasture, S.M.; Dudek, B.; Haber, J. Effect of various water-miscible solvents on enzymatic activity of fungal laccases. J. Mol. Catal. B Enzym. 2000, 11, 1–11. [Google Scholar] [CrossRef]
- Wlizło, K.; Polak, J.; Jarosz-Wilkołazka, A.; Pogni, R.; Petricci, E. Novel textile dye obtained through transformation of 2-amino-3-methoxybenzoic acid by free and immobilised laccase from a Pleurotus ostreatus strain. Enzym. Microb. Technol. 2020, 132, 109398. [Google Scholar] [CrossRef] [PubMed]
- Abdu-Allah, H.H.; El-Shorbagi, A.; Abdel-Moty, S.G.; El-Awady, R.; Abdel-Alim, A. 5-Aminosalyclic acid (5-ASA): A unique anti-inflammatory salicylate. Med. Chem. 2016, 6, 306–315. [Google Scholar] [CrossRef]
- Carceller, E.; Salas, J.; Merlos, M.; Giral, M.; Ferrando, R.; Escamilla, I.; Ramis, J.; García-Rafanell, J.; Forn, J. Novel azo derivatives as prodrugs of 5-aminosalicylic acid and amino derivatives with potent platelet activating factor antagonist activity. J. Med. Chem. 2001, 44, 3001–3013. [Google Scholar] [CrossRef] [PubMed]
- Yousefi, S.; Bayat, S.; Rahman, M.B.A.; Ismail, I.S.; Saki, E.; Abdulmalek, E. Synthesis and in vitro bioactivity evaluation of new glucose and xylitol ester derivatives of 5-aminosalicylic acid. RSC Adv. 2015, 5, 97295–97307. [Google Scholar] [CrossRef]
- Yousefi, S.; Bayat, S.; Rahman, M.B.A.; Ismail, I.S.; Saki, E.; Leong, S.W.; Abdulmalek, E. Synthesis, bioactivity evaluation, and docking study of 5-aminosalicylic acid’s fatty acid derivatives. Monatsh. Chem. 2015, 146, 2139–2149. [Google Scholar] [CrossRef]
- Jasim, E.Q.; Muhammad-Ali, M.A.; Almakki, A. Synthesis, characterization, and antibacterial activity of some mesalazine derivatives. Sci. Technol. Indones. 2023, 8, 338–343. [Google Scholar] [CrossRef]
- Patil, C.J.; Nehete, C.A. The azo derivatives of salicylic acid. Int. J. Pharm. Sci. Rev. Res. 2015, 33, 248–256. [Google Scholar]
- Xu, J.; Chen, N.; Wu, Z.; Song, Y.; Zhang, Y.; Wu, N.; Zhang, F.; Ren, X.; Liu, Y. 5-Aminosalicylic acid alters the gut bacterial microbiota in patients with ulcerative colitis. Front. Microbiol. 2018, 9, 1274. [Google Scholar] [CrossRef]
- Liu, F.; Ma, R.; Riordan, S.M.; Grimm, M.C.; Liu, L.; Wang, Y.; Zhang, L. Azathioprine, mercaptopurine, and 5-aminosalicylic acid affect the growth of IBD-associated Campylobacter species and other enteric microbes. Front. Microbiol. 2017, 8, 527. [Google Scholar] [CrossRef] [PubMed]
- Jaszek, M.; Osinska-Jaroszuk, M.; Janusz, G.; Matuszewska, A.; Stefaniuk, D.; Sulej, J.; Polak, J.; Ruminowicz, M.; Grzywnowicz, K.; Jarosz-Wilkolazka, A. New bioactive fungal molecules with high antioxidant and antimicrobial capacity isolated from Cerrena unicolor idiophasic cultures. Biomed. Res. Int. 2013, 2023, 497492. [Google Scholar] [CrossRef]
- Anita, S.H.; Zulfiana, D.; Digita, A.; Nuha, N.; Syafriana, V.; Febriani, A.; Yanto, D.H.Y. The first evidence of potential antibacterial activity of laccase enzyme from indonesian white rot fungi against pathogenic bacteria. HAYATI J. Bios. 2024, 31, 133–144. [Google Scholar] [CrossRef]
- Ambily, R.; Kour, M.; Shynu, M.; Bhatia, B.; Aravindakshan, T. Evaluation of antibacterial activity of laccase from Bacillus subtilis. Int. J. Curr. Microbiol. App. Sci. 2020, 9, 2960–2963. [Google Scholar] [CrossRef]
- Klaus, J.A.; Brooks, T.M.; Zhou, M.; Veinot, A.J.; Warman, A.M.; Palayew, A.; Gormley, P.T.; Ninh Khuong, B.; Vogels, C.M.; Masuda, J.D. Synthesis, characterization, and antimicrobial activities of palladium Schiff base complexes derived from aminosalicylic acids. Transit. Met. Chem. 2017, 42, 263–271. [Google Scholar] [CrossRef]
- Shehab, A.K.; Rasheed, M.K. Synthesis, characterization and antibacterial activity of thiazolidine-4-one and imidazolidine-4-one derived from Mesalazine drug by microwave method. Int. J. Health Sci. 2022, 6, 12446–12456. [Google Scholar] [CrossRef]
- Lazić, V.; Smičiklas, I.; Marković, J.; Lončarević, D.; Dostanić, J.; Ahrenkiel, S.P.; Nedeljković, J.M. Antibacterial ability of supported silver nanoparticles by functionalized hydroxyapatite with 5-aminosalicylic acid. Vacuum 2018, 148, 62–68. [Google Scholar] [CrossRef]
- Barclay, L.R.C.; Winqvist, M.R. Phenols as antioxidants. In The Chemistry of Phenols; Rappoport, Z., Ed.; John Wiley & Sons: Chichester, UK, 2003; pp. 839–908. [Google Scholar]
- Pérez, L.C.C.; Sánchez, M.G.; Wejebe, J.E.M.; Rgodríguez, M.H.; Vázquez, M.J.F.; Salazar, J.R.; Basurto, J.C.; Martínez, I.I.P.; Hernández, M.C.R. Novel 5-aminosalicylic derivatives as anti-inflammatories and myeloperoxidase inhibitors evaluated in silico, in vitro and ex vivo. Arab. J. Chem. 2019, 12, 5278–5291. [Google Scholar] [CrossRef]
- Yousefi, S.; Bayat, S.; Rahman, M.B.A.; Ibrahim, Z.; Abdulmalek, E. Synthesis and in vitro bioactivity evaluation of new galactose and fructose ester derivatives of 5-aminosalicylic acid. Chem. Biodiver. 2017, 14, e1600362. [Google Scholar] [CrossRef]
- Polak, J.; Grąz, M.; Wlizło, K.; Szałapata, K.; Kapral-Piotrowska, J.; Paduch, R.; Jarosz-Wilkołazka, A. Bioactive properties of a novel antibacterial dye obtained from laccase-mediated oxidation of 8-anilino-1-naphthalenesulfonic acid. Molecules 2022, 27, 487. [Google Scholar] [CrossRef] [PubMed]
- Polish Committee for Standardization. Available online: https://www.pkn.pl/polskie-normy (accessed on 18 May 2020).
- Luterek, J.; Gianfreda, L.; Wojta’s-Wasilewska, M.; Rogalski, J.; Jaszek, M.; Malarczyk, E.; Dawidowicz, A.; Ginalska, G.; Leonowicz, A.; Finks-Boots, M. Screening of the wood rotting fungi for laccase production: Induction by ferulic acid, partial purification, and immobilization of laccase from the high laccase-producing strain, Cerrena unicolor. Acta Microbiol. Pol. 1997, 46, 297–311. [Google Scholar]
- Bernhardt, F.-H.; Staudinger, H.; Ulrich, V. The properties of p-anisate O-demethylase in cell-free extracts of Pseudomonas sp. Hoppe-Seyler’s Z. Physiol. Chem. 1970, 351, 467–478. [Google Scholar] [CrossRef]
- Clinical and Laboratory Standards Institute (CLSI). Performance Standards for Antimicrobial Disk Susceptibility Tests; Approved Standard—Eleventh Edition. CLSI document M02-A11; Clinical and Laboratory Standards Institute: Wayne, PA, USA, 2012. [Google Scholar]
- Clinical and Laboratory Standards Institute (CLSI). Performance Standards for Antimicrobial Susceptibility Testing, 30th, ed.; CLSI supplement M100. CLSI document M02-A11; Clinical and Laboratory Standards Institute: Wayne, PA, USA, 2020. [Google Scholar]
- Clinical and Laboratory Standards Institute (CLSI). Methods for Dilution Antimicrobial Susceptibility Tests for Bacteria That Grow Aerobically; Approved Standard—Ninth Edition. CLSI Document M07-A9; Clinical and Laboratory Standards Institute: Wayne, PA, USA, 2012. [Google Scholar]
- Product Test Guidelines for the Assessment of Human Skin Compatibility. 1997. Available online: https://www.cosmeticseurope.eu/files/6014/6407/8875/Product_Test_Guidelines_for_the_Assessment_of_Human_Skin_Compatibility_-_1997.pdf (accessed on 18 May 2020).
- Guidelines for the Evaluation of the Efficacy of Cosmetic Products. 2008. Available online: https://cosmeticseurope.eu/files/4214/6407/6830/Guidelines_for_the_Evaluation_of_the_Efficacy_of_Cosmetic_Products_-_2008.pdf (accessed on 18 May 2020).
- Statsoft Inc. Statistica for Windows (Data Analysis System), version 13.3; Statsoft Inc.: Tulsa, OK, USA, 2021. [Google Scholar]

| Structure | Eo vs. NHE (V) | Spectrum of Product | λ max (nm) | KM (mM) | Oxygen Demand (nM/min/mL) |
|---|---|---|---|---|---|
![]() | 0.494 0.734 | ![]() | 500 | 0.49 | 1017 |
| Acronym of Tested Compound | Final Concentration of Buffer before Lyophilisation (%) | Concentration of Salt (M) before Lyophilisation | 5-ASA (mg/mL) | pH of Mixture | Content of Impurities in Dry Product (%) |
|---|---|---|---|---|---|
| S | 0 | 0 | 33 | 9.5 | 0 |
| C | 20 | 0.04 | 0 | 5 | 100 |
| Dye30B | 30 | 0.06 | 1 | 6.35 | 88 |
| Dye20B | 20 | 0.04 | 0.6 | 5.33 | 89 |
| Dye16B | 16 | 0.032 | 1 | 5.09 | 48 |
| Dye2B | 2 | 0.004 | 0.6 | 5.26 | 51 |
| Tested Compound | Inhibition Zone [mm] | ||
|---|---|---|---|
| E. coli ATCC® 25922TM 0.2 × 106 cfu/mL | S. aureus ATCC® 25923TM 1.4 × 106 cfu/mL | S. epidermidis ATCC® 14990TM 0.8 × 106 cfu/mL | |
| S | - | - | - |
| C | - | - | - |
| Dye30B | - | - | - |
| Dye16B | - | 3 | 7 |
| Dye2B | - | 3 | 6.5 |
| Tested Sample | Staphylococcus aureus 2.96 × 102 cfu/mL | Staphylococcus epidermidis 5.19 × 102 cfu/mL | ||
|---|---|---|---|---|
| MIC (mg/mL) | MBC (mg/mL) | MIC (mg/mL) | MBC (mg/mL) | |
| S | - | - | - | - |
| C | - | - | - | - |
| Dye30B | - | - | - | - |
| Dye20B | 0.9 | >1 | 0.5 | 1 |
| Dye16B | 0.5 | 0.6 | 0.125 | 0.5 |
| Dye2B | 0.125 | 0.6 | 0.125 | 0.5 |
| Tested Sample | IC50 (µg/mL) |
|---|---|
| S | 1.3 |
| C | 19.2 |
| Dye30B | 43 |
| Dye20B | 31.5 |
| Dye16B | 15.4 |
| Dye2B | 8.0 |
| Tested Sample | IC50 (µg/mL) | |
|---|---|---|
| MTT | LDH | |
| S | 1285 | 1125 |
| C | 1041 | 1321 |
| Dye30B | 550 | 721 |
| Dye20B | 781 | 796 |
| Dye16B | 906 | 833 |
| Dye2B | 146 | 196 |
| Tested Sample | 5 min | 15 min |
|---|---|---|
| S | 55 | 63 |
| Dye20B | 112 | 95 |
| Photo of Dyed Wool | Tested Parameters of Colour Fastness | Scale * | ISO Standard [33] | |
|---|---|---|---|---|
![]() | Artificial light (1) | (a) | 3 | PN-EN ISO 105-B02:2014-11 |
| Distilled water (2) | (a) | 3–4 | PN-EN ISO 105-E01:2013-06 | |
| (b) | 2 | |||
| (c) | 3 | |||
| Washing 40 °C (2) | (a) | 4 | PN-EN ISO 105-C06:2010 | |
| (b) | 4–5 | |||
| (c) | 4–5 | |||
| Alkaline sweat (2) | (a) | 3–4 | PN-EN ISO 105-E04:2013-06 | |
| (b) | 2 | |||
| (c) | 3–4 | |||
| Acidic sweat (2) | (a) | 3–4 | PN-EN ISO 105-E01:2013-06 | |
| (b) | 1–2 | |||
| (c) | 2–3 | |||
| Dry rubbing (2) | (b) | 4–5 | PN-EN ISO 105-X12:2005 | |
| Wet rubbing (2) | (b) | 4 | PN-EN ISO 105-X12:2005 | |
| Characteristics of the Volunteer | Results of the Test | Characteristics of the Volunteer | Results of the Test | ||||||||
|---|---|---|---|---|---|---|---|---|---|---|---|
| No | Gender | Age | Skin Type | 48 h | 72 h | No | Gender | Age | Skin Type | 48 h | 72 h |
| 1 | M | 33 | S | - | - | 26 | M | 65 | S | - | - |
| 2 | F | 28 | S | - | - | 27 | F | 70 | S | - | - |
| 3 | F | 50 | S | - | - | 28 | M | 40 | S | - | - |
| 4 | F | 54 | S,A | - | - | 29 | F | 37 | S | - | - |
| 5 | F | 42 | S | - | - | 30 | M | 40 | S | - | - |
| 6 | F | 39 | S | - | - | 31 | F | 20 | S | - | - |
| 7 | F | 26 | S | - | - | 32 | M | 67 | S | - | - |
| 8 | F | 70 | S | - | - | 33 | M | 38 | S | - | - |
| 9 | F | 49 | S | - | - | 34 | M | 69 | S | - | - |
| 10 | M | 51 | S,A | - | - | 35 | M | 66 | S | - | - |
| 11 | M | 70 | S | - | - | 36 | F | 33 | S | - | - |
| 12 | F | 33 | S | - | - | 37 | F | 65 | S | - | - |
| 13 | F | 19 | S | - | - | 38 | F | 35 | S | - | - |
| 14 | F | 53 | S | - | - | 39 | F | 40 | S | - | - |
| 15 | F | 22 | S | - | - | 40 | F | 31 | S | - | - |
| 16 | F | 22 | S | - | - | 41 | F | 40 | S | - | - |
| 17 | M | 30 | S,A | - | - | 42 | F | 41 | S | - | - |
| 18 | F | 23 | S | - | - | 43 | F | 24 | S | - | - |
| 19 | F | 50 | S | - | - | 44 | F | 24 | S | - | - |
| 20 | F | 70 | S | - | - | 45 | F | 35 | S | - | - |
| 21 | M | 40 | S | - | - | 46 | M | 27 | S | - | - |
| 22 | M | 69 | S | - | - | 47 | F | 54 | S | - | - |
| 23 | M | 23 | S | - | - | 48 | F | 31 | S,A | - | - |
| 24 | F | 70 | S | - | - | 49 | F | 31 | S,A | - | - |
| 25 | M | 36 | S | - | - | 50 | F | 29 | S | - | - |
Disclaimer/Publisher’s Note: The statements, opinions and data contained in all publications are solely those of the individual author(s) and contributor(s) and not of MDPI and/or the editor(s). MDPI and/or the editor(s) disclaim responsibility for any injury to people or property resulting from any ideas, methods, instructions or products referred to in the content. |
© 2024 by the authors. Licensee MDPI, Basel, Switzerland. This article is an open access article distributed under the terms and conditions of the Creative Commons Attribution (CC BY) license (https://creativecommons.org/licenses/by/4.0/).
Share and Cite
Polak, J.; Grąz, M.; Szałapata, K.; Kapral-Piotrowska, J.; Wlizło, K.; Polak, M.; Jarosz-Wilkołazka, A. Synthesis and Bioactive Properties of the Novel Coloured Compound Obtained via the Laccase-Mediated Transformation of 5-Aminosalicylic Acid. Molecules 2024, 29, 1310. https://doi.org/10.3390/molecules29061310
Polak J, Grąz M, Szałapata K, Kapral-Piotrowska J, Wlizło K, Polak M, Jarosz-Wilkołazka A. Synthesis and Bioactive Properties of the Novel Coloured Compound Obtained via the Laccase-Mediated Transformation of 5-Aminosalicylic Acid. Molecules. 2024; 29(6):1310. https://doi.org/10.3390/molecules29061310
Chicago/Turabian StylePolak, Jolanta, Marcin Grąz, Katarzyna Szałapata, Justyna Kapral-Piotrowska, Kamila Wlizło, Marcin Polak, and Anna Jarosz-Wilkołazka. 2024. "Synthesis and Bioactive Properties of the Novel Coloured Compound Obtained via the Laccase-Mediated Transformation of 5-Aminosalicylic Acid" Molecules 29, no. 6: 1310. https://doi.org/10.3390/molecules29061310
APA StylePolak, J., Grąz, M., Szałapata, K., Kapral-Piotrowska, J., Wlizło, K., Polak, M., & Jarosz-Wilkołazka, A. (2024). Synthesis and Bioactive Properties of the Novel Coloured Compound Obtained via the Laccase-Mediated Transformation of 5-Aminosalicylic Acid. Molecules, 29(6), 1310. https://doi.org/10.3390/molecules29061310




